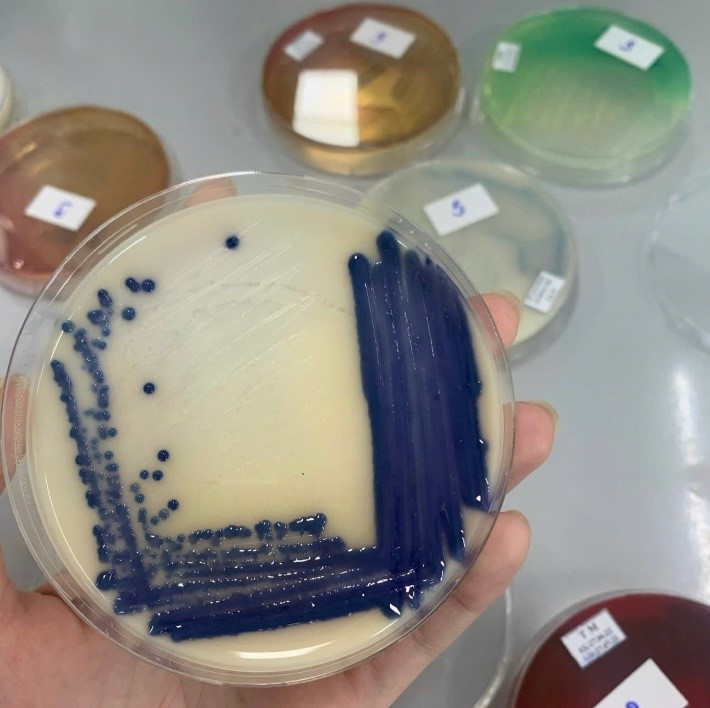
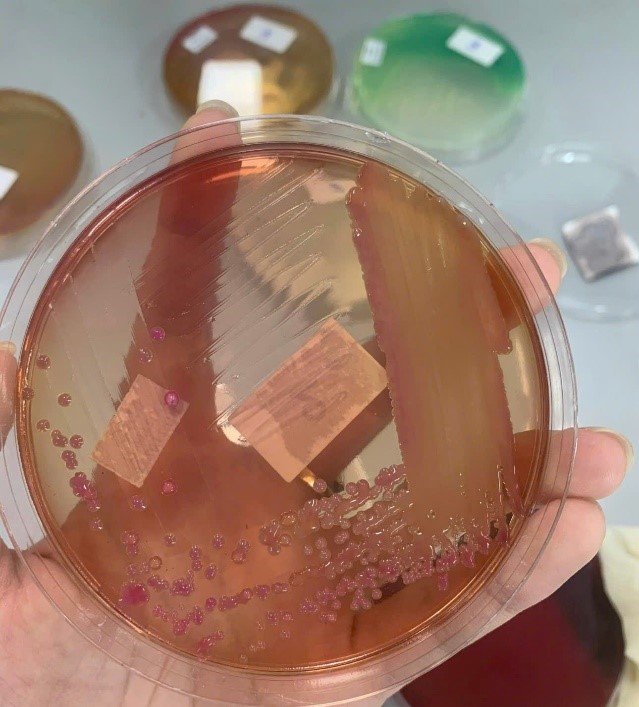
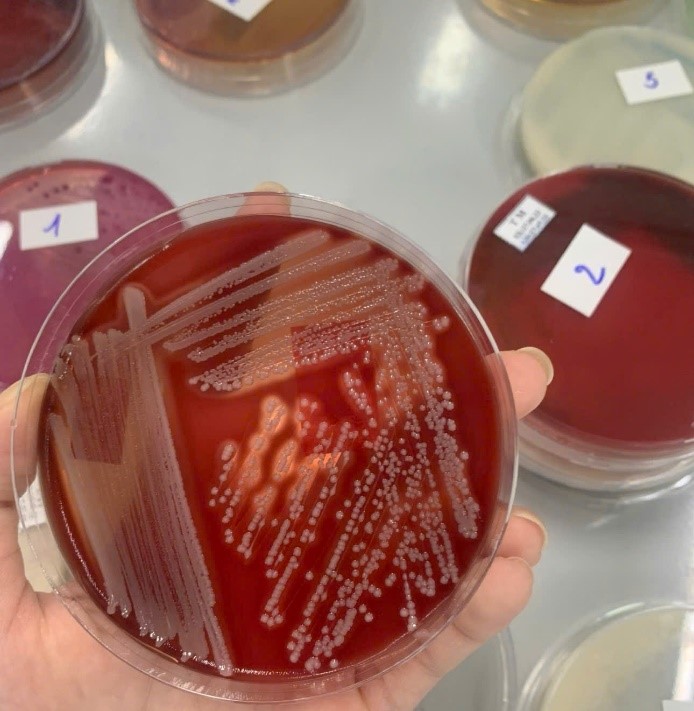
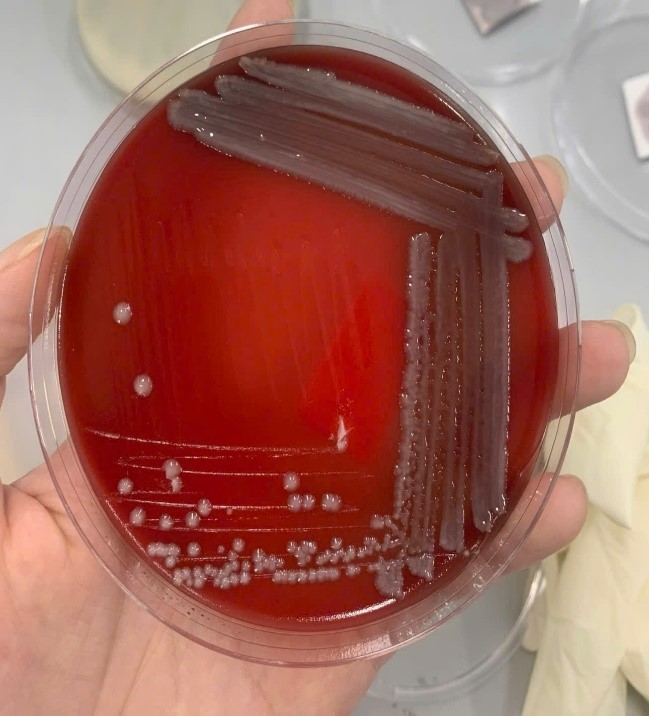

BẮT ĐẦU TỪ NHỮNG MẪU BỆNH PHẨM ĐẦU TIÊN
Một ngày làm việc của Khoa Vi sinh thường bắt đầu rất sớm. Ngay đầu giờ sáng, khu vực tiếp nhận mẫu đã nhộn nhịp. Hàng trăm mẫu bệnh phẩm từ các khoa, phòng và đơn vị gửi ngoài được chuyển đến: Máu, đờm, nước tiểu, phân, dịch não tủy, dịch ổ áp-xe…
Mỗi mẫu bệnh phẩm đều được kiểm tra kỹ thông tin: Họ tên, mã bệnh án, khoa gửi, loại mẫu, thời gian lấy mẫu, chỉ định xét nghiệm… Từng bước mã hóa, nhập hệ thống, phân loại và chuyển tới khu vực xét nghiệm phù hợp đều phải được thực hiện chính xác, vì mỗi mẫu tương ứng với một người bệnh thật, một gia đình thật, một niềm hy vọng thật.

TỈ MỈ TRONG TỪNG THAO TÁC
Ở mỗi khu vực chuyên môn, kỹ thuật viên lại tiếp tục “câu chuyện” của mẫu bệnh phẩm theo cách riêng:
– Tại khu nuôi cấy – định danh vi khuẩn, mẫu được cấy lên môi trường chuyên biệt, ủ ở điều kiện nhiệt độ, thời gian phù hợp. Những chấm nhỏ li ti trên môi trường sau 18-24 giờ chính là “dấu vết” của tác nhân gây bệnh.
|
|
|
|
– Ở khu miễn dịch, mẫu huyết thanh được đưa lên các hệ thống xét nghiệm hiện đại để tìm kiếm kháng nguyên, kháng thể đặc hiệu.
– Khu xét nghiệm lao, virus lại đòi hỏi yêu cầu rất nghiêm ngặt về an toàn sinh học, từ trang phục phòng hộ đến quy trình xử lý mẫu.
Mỗi thao tác đều cần sự tập trung cao độ, tỉ mỉ và tuân thủ đúng quy trình. Một sai sót nhỏ có thể ảnh hưởng đến độ chính xác của kết quả, từ đó tác động trực tiếp đến quyết định điều trị của bác sĩ và sức khỏe người bệnh.
 |
 |
 |
 |
KHÔNG CHỈ LÀM VIỆC TRONG GIỜ HÀNH CHÍNH
Nhịp độ công việc tại Khoa Vi sinh không dừng lại khi hết giờ làm. Những cuộc gọi từ khoa Cấp cứu, Hồi sức tích cực… yêu cầu xét nghiệm khẩn có thể đến bất cứ lúc nào. Đằng sau những kết quả “cần gấp” là sự chạy đua với thời gian của các bác sĩ, kỹ thuật viên vi sinh: Tiếp nhận mẫu ngay khi vừa nhận được thông tin, ưu tiên xử lý, rút ngắn tối đa thời gian chờ nhưng vẫn đảm bảo đủ các bước kiểm soát chất lượng.
Khoa Vi sinh cũng thường xuyên trao đổi với các bác sĩ lâm sàng. Nhiều trường hợp, nhờ kết quả vi sinh chính xác, phác đồ kháng sinh được điều chỉnh kịp thời, giúp người bệnh cải thiện nhanh hơn và giảm nguy cơ kháng kháng sinh.

“HẬU TRƯỜNG” ĐẢM BẢO CHẤT LƯỢNG XÉT NGHIỆM
Ít ai biết rằng để có một kết quả xét nghiệm tin cậy, phía sau còn là cả hệ thống kiểm soát chất lượng chặt chẽ:
– Máy móc, thiết bị được kiểm tra, bảo dưỡng, hiệu chuẩn định kỳ.
– Hóa chất, sinh phẩm, môi trường nuôi cấy được bảo quản đúng quy định, kiểm tra trước khi sử dụng.
– Quy trình xử lý, trả kết quả thường xuyên được chuẩn hóa, cập nhật theo các hướng dẫn chuyên môn.
Đây là phần việc thầm lặng nhưng là “xương sống” của chất lượng xét nghiệm, góp phần quan trọng vào uy tín chuyên môn của bệnh viện.
 |
 |

💚NHỮNG NGƯỜI HÙNG PHÍA SAU ỐNG NGHIỆM VÀ KÍNH HIỂN VI
Nhiều kỹ thuật viên chia sẻ, họ ít khi gặp trực tiếp người bệnh nhưng luôn ý thức rõ rằng phía sau mỗi mẫu bệnh phẩm là một cuộc đời, một gia đình đang chờ đợi. Niềm vui của họ đôi khi chỉ là một ca bệnh nặng cải thiện sau khi điều chỉnh kháng sinh dựa trên kết quả vi sinh, hay một ổ dịch được kiểm soát nhờ phát hiện sớm tác nhân gây bệnh.
Một ngày làm việc tại Khoa Vi sinh Bệnh viện Bạch Mai không chỉ là thao tác kỹ thuật lặp lại, mà là hành trình kết nối dữ liệu – bằng chứng – quyết định điều trị. Khoa Vi sinh có thể không thường xuyên xuất hiện trước mắt người bệnh, nhưng luôn hiện diện trong từng kết quả xét nghiệm, từng quyết định điều trị, từng ca bệnh hồi phục.

“Trân trọng những công việc thầm lặng ❤️❤️”




